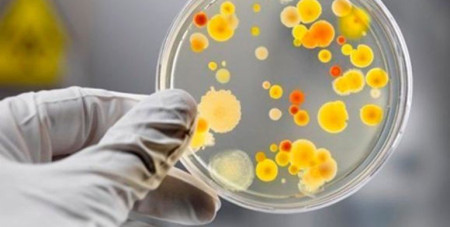

Причиною отруєння на поминальному обіді в Ківерцях стала сальмонела
Медики розповіли про причини масового отруєння після поминального обіду в Ківерцях. Лікарі припускають, що бактерія сальмонели могла бути в салаті з куркою.
Про це пише Волинь.
Як уже повідомлялося, у Ківерцях у місцевому кафе торгового центру «Україна» під час поминального обіду отруїлося п’ятеро людей. Серед хворих є й сім’я. У всіх постраждалих діагностували харчове отруєння.
Людям стало погано через 10 годин після вживання їжі. Всі скаржилися на високу температуру, нудоту, кишкові розлади. Хворих госпіталізовано.
Після дослідження їжі, яку споживали, медики припустили, що бактерія сальмонели могла бути в салаті з куркою.
«У цій страві, якщо не дотримуватися температурного режиму і терміну зберігання, сальмонела швидко розмножується», – зазначила лікар-епідеміолог Волинського лабораторного центру МОЗ України Валентина Новачевська.
За даними епідеміологів, це вже четвертий спалах сальмонельозу за пів року. Лікарі припускають, що люди отруїлися їжею, яку приготували заздалегідь і неналежно зберігали.
Підписуйтесь на наш Telegram-канал, аби першими дізнаватись найактуальніші новини Волині, України та світу
Про це пише Волинь.
Як уже повідомлялося, у Ківерцях у місцевому кафе торгового центру «Україна» під час поминального обіду отруїлося п’ятеро людей. Серед хворих є й сім’я. У всіх постраждалих діагностували харчове отруєння.
Людям стало погано через 10 годин після вживання їжі. Всі скаржилися на високу температуру, нудоту, кишкові розлади. Хворих госпіталізовано.
Після дослідження їжі, яку споживали, медики припустили, що бактерія сальмонели могла бути в салаті з куркою.
«У цій страві, якщо не дотримуватися температурного режиму і терміну зберігання, сальмонела швидко розмножується», – зазначила лікар-епідеміолог Волинського лабораторного центру МОЗ України Валентина Новачевська.
За даними епідеміологів, це вже четвертий спалах сальмонельозу за пів року. Лікарі припускають, що люди отруїлися їжею, яку приготували заздалегідь і неналежно зберігали.
Знайшли помилку? Виділіть текст і натисніть
Підписуйтесь на наш Telegram-канал, аби першими дізнаватись найактуальніші новини Волині, України та світу

Коментарів: 0
Чому коти живуть довше за собак: відповідь вчених здивує
Сьогодні 00:27
Сьогодні 00:27
Більшість українців проти офіційного статусу російської мови, лише 5% – за «другу державну»
15 Червня 2026 23:38
15 Червня 2026 23:38
Двох громадян України та Румунії визнали винними у підпалах майна премʼєра Британії Кіра Стармера
15 Червня 2026 23:18
15 Червня 2026 23:18
Сина кронпринцеси Норвегії засудили до 4 років тюрми за зґвалтування двох жінок
15 Червня 2026 23:00
15 Червня 2026 23:00
Ізраїль відмовився дотримуватися угоди, укладеної між США та Іраном
15 Червня 2026 22:40
15 Червня 2026 22:40
Загарбники вдарили по зоопарку в Харкові, загинули тварини
15 Червня 2026 22:22
15 Червня 2026 22:22
За два тижні на Волині у ДТП постраждали 46 дітей
15 Червня 2026 22:02
15 Червня 2026 22:02
У Польщі пояснили, за яких умов передадуть Україні обіцяні МіГи
15 Червня 2026 21:43
15 Червня 2026 21:43
Пенсії суддів і депутатів в Україні сягають мільйонів: хто отримує найбільше
15 Червня 2026 21:23
15 Червня 2026 21:23


























.png)

Додати коментар:
УВАГА! Користувач www.volynnews.com має розуміти, що коментування на сайті створені аж ніяк не для політичного піару чи антипіару, зведення особистих рахунків, комерційної реклами, образ, безпідставних звинувачень та інших некоректних і негідних речей. Утім коментарі – це не редакційні матеріали, не мають попередньої модерації, суб’єктивні повідомлення і можуть містити недостовірну інформацію.